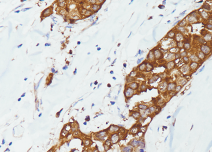

nm23抗体试剂
nm23抗体试剂
核苷二磷酸激酶
产品描述
nm23抗体是一种特异性识别nm23蛋白(又称核苷二磷酸激酶)的免疫检测工具,该蛋白家族包含nm23-H1和nm23-H2两种亚型,在调控细胞增殖、分化及转移中发挥重要作用。nm23抗体在肿瘤研究中具有重要价值,其表达水平与肿瘤转移潜能呈负相关——高表达nm23的乳腺癌、胃癌等恶性肿瘤往往表现出较低的转移倾向和较好的预后。该抗体在免疫组化检测中主要呈现胞质阳性染色,可用于评估多种上皮源性肿瘤(如乳腺癌、肝癌、肺癌等)的转移风险,其表达缺失提示肿瘤更具侵袭性。值得注意的是,nm23在黑色素瘤中的表达模式与上皮性肿瘤相反,高表达反而与不良预后相关,这种组织特异性差异使得nm23抗体在临床病理诊断中需要结合具体肿瘤类型进行解读。
参考文献
产品信息
备案名称:
nm23抗体试剂
备案证号:
粤深械备 20221690
产品型号:
DMRD0237
适用:
阳性部位:
细胞质
预 处 理:
EDTA 热修复
产品规格
| 类型 | 即用型 | 浓缩型 | ||||
| 规格 | 1ml | 3ml | 6ml | 10ml | 0.1ml | 0.2ml |


